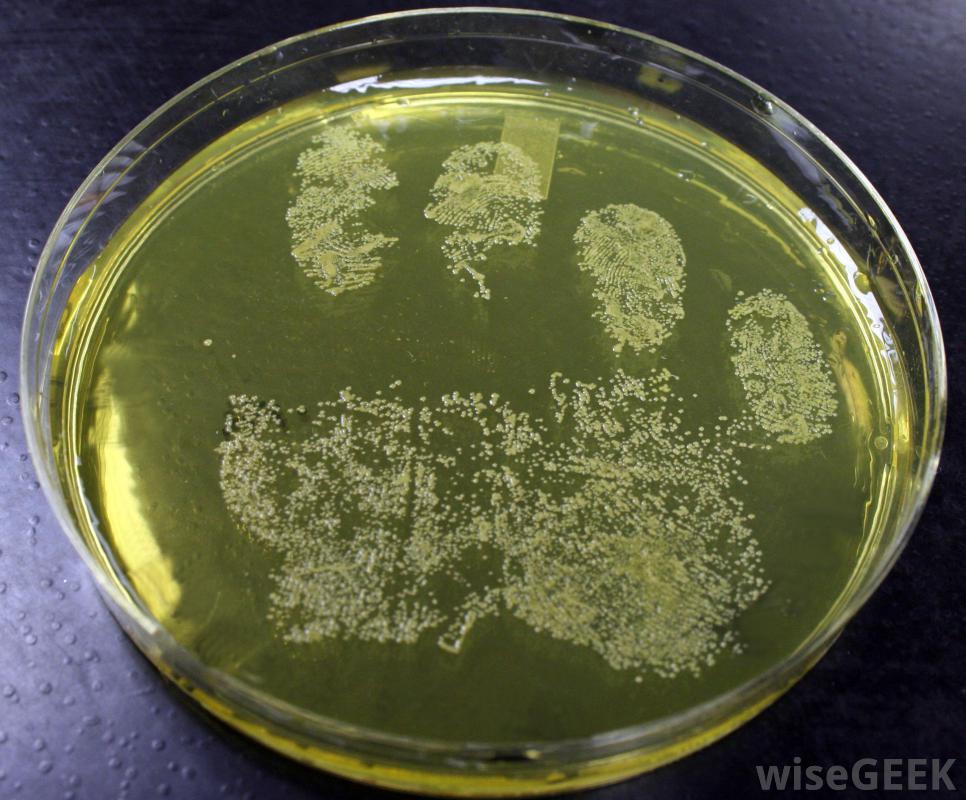

什么是革蘭氏陰性抗生素(What Gram Negative Antibiotics)?
革蘭氏陰性抗生素是一種對革蘭氏陰性菌(如大腸桿菌)感染有效的藥物。這些感染很難治療,因為細菌能抵抗許多常見的抗生素,而且不能用廣譜藥物治療,可能有必要使用一種非常特殊的配方,這就要求醫生進行檢查,找出是哪種微生物引...
革蘭氏陰性抗生素是一種對革蘭氏陰性菌(如大腸桿菌)感染有效的藥物。這些感染很難治療,因為細菌能抵抗許多常見的抗生素,而且不能用廣譜藥物治療,可能有必要使用一種非常特殊的配方,這就要求醫生進行檢查,找出是哪種微生物引起了感染,而不是給病人提供一種基本的抗生素,希望它能起作用src="/img/0730/staph-colony.jpg"/>陰性抗生素會引起頭痛等副作用。革蘭氏陰性菌和革蘭氏陽性菌的區別取決于它們在革蘭氏染色中的表現,一種實驗室測試,技術人員將細胞暴露在結晶紫中,然后反沖洗它們看它們是否保持顏色。如果細菌染色,革蘭氏陽性。革蘭氏陰性菌不會染色,因為它們的細胞壁結構不同。這些差異被證明是決定微生物對哪種抗生素有反應的關鍵。革蘭氏陽性菌對抗生素更敏感,通常可以用廣譜藥物治療藥物。 如果患者對革蘭氏陰性抗生素有過敏反應,應咨詢醫生革蘭氏陰性抗生素的設計者必須開發出能夠穿透革蘭氏陰性菌細胞膜向機體輸送致命藥物的藥物,而且每一個細胞壁都是不同的,這使得這一點具有挑戰性。這些藥物可能會干擾細胞壁的合成、細菌的繁殖或新陳代謝,細菌培養可用于鑒定抗生素對特定感染的有效性與泌尿、呼吸道和胃腸道感染相關的細菌通常為革蘭氏陰性。治療此類感染的醫生需要選擇適當的革蘭氏陰性抗生素來治療患者的病情。如果醫生使用如果使用了錯誤的藥物,細菌不會產生反應,感染會變得更嚴重。像鏈霉素這樣的氨基糖苷類抗生素就是革蘭氏陰性抗生素的例子。隨著時間的推移,由于服用處方抗生素時不良的習慣,細菌仍會對其產生耐藥性
如果患者對革蘭氏陰性抗生素有過敏反應,應咨詢醫生革蘭氏陰性抗生素的設計者必須開發出能夠穿透革蘭氏陰性菌細胞膜向機體輸送致命藥物的藥物,而且每一個細胞壁都是不同的,這使得這一點具有挑戰性。這些藥物可能會干擾細胞壁的合成、細菌的繁殖或新陳代謝,細菌培養可用于鑒定抗生素對特定感染的有效性與泌尿、呼吸道和胃腸道感染相關的細菌通常為革蘭氏陰性。治療此類感染的醫生需要選擇適當的革蘭氏陰性抗生素來治療患者的病情。如果醫生使用如果使用了錯誤的藥物,細菌不會產生反應,感染會變得更嚴重。像鏈霉素這樣的氨基糖苷類抗生素就是革蘭氏陰性抗生素的例子。隨著時間的推移,由于服用處方抗生素時不良的習慣,細菌仍會對其產生耐藥性 革蘭氏陰性抗生素的一些副作用可能具有潛在的危險性。與其他抗生素一樣,這些藥物會引起惡心、頭痛等副作用,還有皮疹病人在某些情況下可能會有過敏反應,在這種情況下,他們會出現急性癥狀,如呼吸困難、皮膚起泡和蕁麻疹。如果病人對革蘭氏陰性抗生素有過敏反應,建議咨詢醫生以獲得快速治療,包括替代抗生素治療沒有引發另一種過敏反應的患者。如果患者有不良反應史,這將在圖表中注明,以防止患者意外服用不應服用的藥物。
革蘭氏陰性抗生素的一些副作用可能具有潛在的危險性。與其他抗生素一樣,這些藥物會引起惡心、頭痛等副作用,還有皮疹病人在某些情況下可能會有過敏反應,在這種情況下,他們會出現急性癥狀,如呼吸困難、皮膚起泡和蕁麻疹。如果病人對革蘭氏陰性抗生素有過敏反應,建議咨詢醫生以獲得快速治療,包括替代抗生素治療沒有引發另一種過敏反應的患者。如果患者有不良反應史,這將在圖表中注明,以防止患者意外服用不應服用的藥物。 區別革蘭氏陰性菌和革蘭氏陽性菌之間的關系取決于它們在某些實驗室測試中的表現。
區別革蘭氏陰性菌和革蘭氏陽性菌之間的關系取決于它們在某些實驗室測試中的表現。 與尿路感染相關的細菌通常為革蘭氏陰性與尿路感染相關的細菌通常為革蘭氏陰性陰性抗生素可用于治療大腸桿菌。
與尿路感染相關的細菌通常為革蘭氏陰性與尿路感染相關的細菌通常為革蘭氏陰性陰性抗生素可用于治療大腸桿菌。
 如果患者對革蘭氏陰性抗生素有過敏反應,應咨詢醫生革蘭氏陰性抗生素的設計者必須開發出能夠穿透革蘭氏陰性菌細胞膜向機體輸送致命藥物的藥物,而且每一個細胞壁都是不同的,這使得這一點具有挑戰性。這些藥物可能會干擾細胞壁的合成、細菌的繁殖或新陳代謝,細菌培養可用于鑒定抗生素對特定感染的有效性與泌尿、呼吸道和胃腸道感染相關的細菌通常為革蘭氏陰性。治療此類感染的醫生需要選擇適當的革蘭氏陰性抗生素來治療患者的病情。如果醫生使用如果使用了錯誤的藥物,細菌不會產生反應,感染會變得更嚴重。像鏈霉素這樣的氨基糖苷類抗生素就是革蘭氏陰性抗生素的例子。隨著時間的推移,由于服用處方抗生素時不良的習慣,細菌仍會對其產生耐藥性
如果患者對革蘭氏陰性抗生素有過敏反應,應咨詢醫生革蘭氏陰性抗生素的設計者必須開發出能夠穿透革蘭氏陰性菌細胞膜向機體輸送致命藥物的藥物,而且每一個細胞壁都是不同的,這使得這一點具有挑戰性。這些藥物可能會干擾細胞壁的合成、細菌的繁殖或新陳代謝,細菌培養可用于鑒定抗生素對特定感染的有效性與泌尿、呼吸道和胃腸道感染相關的細菌通常為革蘭氏陰性。治療此類感染的醫生需要選擇適當的革蘭氏陰性抗生素來治療患者的病情。如果醫生使用如果使用了錯誤的藥物,細菌不會產生反應,感染會變得更嚴重。像鏈霉素這樣的氨基糖苷類抗生素就是革蘭氏陰性抗生素的例子。隨著時間的推移,由于服用處方抗生素時不良的習慣,細菌仍會對其產生耐藥性 革蘭氏陰性抗生素的一些副作用可能具有潛在的危險性。與其他抗生素一樣,這些藥物會引起惡心、頭痛等副作用,還有皮疹病人在某些情況下可能會有過敏反應,在這種情況下,他們會出現急性癥狀,如呼吸困難、皮膚起泡和蕁麻疹。如果病人對革蘭氏陰性抗生素有過敏反應,建議咨詢醫生以獲得快速治療,包括替代抗生素治療沒有引發另一種過敏反應的患者。如果患者有不良反應史,這將在圖表中注明,以防止患者意外服用不應服用的藥物。
革蘭氏陰性抗生素的一些副作用可能具有潛在的危險性。與其他抗生素一樣,這些藥物會引起惡心、頭痛等副作用,還有皮疹病人在某些情況下可能會有過敏反應,在這種情況下,他們會出現急性癥狀,如呼吸困難、皮膚起泡和蕁麻疹。如果病人對革蘭氏陰性抗生素有過敏反應,建議咨詢醫生以獲得快速治療,包括替代抗生素治療沒有引發另一種過敏反應的患者。如果患者有不良反應史,這將在圖表中注明,以防止患者意外服用不應服用的藥物。 區別革蘭氏陰性菌和革蘭氏陽性菌之間的關系取決于它們在某些實驗室測試中的表現。
區別革蘭氏陰性菌和革蘭氏陽性菌之間的關系取決于它們在某些實驗室測試中的表現。 與尿路感染相關的細菌通常為革蘭氏陰性與尿路感染相關的細菌通常為革蘭氏陰性陰性抗生素可用于治療大腸桿菌。
與尿路感染相關的細菌通常為革蘭氏陰性與尿路感染相關的細菌通常為革蘭氏陰性陰性抗生素可用于治療大腸桿菌。
- 發表于 2020-07-30 17:33
- 閱讀 ( 728 )
- 分類:醫療衛生
你可能感興趣的文章
- 什么是盆底功能障礙(Pelvic Floor Dysfunction)? 797 瀏覽
- 什么是插管鎮靜(Intubation Sedation)? 732 瀏覽
- 什么是家庭醫生(Family Doctors)? 652 瀏覽
- 寶釵丸是什么(What Po Chai Pills)? 1063 瀏覽
- 什么是輕度腦震蕩(Mild Concussion)? 798 瀏覽
- 什么是初級保健診所(Primary Care Clinic)? 1026 瀏覽
- 眼球疼痛最常見的原因是什么(Most Common Causes of Eyeball Pain)? 679 瀏覽
- 什么是洋蔥茶(Onion Tea)? 1042 瀏覽
- 什么是腘動脈(Popliteal Artery)? 1083 瀏覽
- 什么是腘動脈(Popliteal Artery)? 996 瀏覽
- 什么是拇指夾板(Thumb Spica Splint)? 1183 瀏覽
- 什么是間接膽紅素(Indirect Bilirubin)? 1704 瀏覽
- 如何選擇最好的銅補充劑(Choose the Best Copper Supplement)? 910 瀏覽
- 最常見的肌肉緊張是什么(Most Commonly Strained Muscles)? 863 瀏覽
- 什么是化療毒性(Chemotherapy Toxicity)? 794 瀏覽
- 什么是內皮細胞(Endothelial Cells)? 1690 瀏覽
- ARBs和ACE抑制劑有什么區別(the Difference between ARBs and ACE Inhibitors)? 766 瀏覽
- 我如何識別骨癌的癥狀(Recognize the Symptoms of Bone Cancer)? 959 瀏覽
- 有哪些不同的醫療補助計劃(Different Medicaid Programs)? 908 瀏覽
- 什么是BNP測試(BNP Test)? 1280 瀏覽
- 醋之母對健康有什么促進作用(Health-Promoting Properties of Mother of Vinegar)? 843 瀏覽
- 什么是空間記憶(Spatial Memory)? 3824 瀏覽
- 什么是預充注射器(Prefilled Syringe)? 3289 瀏覽
- 什么是胎兒壓力測試(Fetal Stress Test )? 928 瀏覽
- 什么是滑膜炎(Funisitis)? 799 瀏覽
- 什么是蒸汽療法(Steam Therapy)? 893 瀏覽
- 雷諾德現象是什么(Raynaud's Phenomenon)? 848 瀏覽
- 什么是放射治療(Radiotherapy)? 792 瀏覽
- 什么是造口威化片(Ostomy Wafer)? 914 瀏覽
- 心臟病發作完全恢復需要多長時間(Long It Take for Full Heart Attack Recovery)? 701 瀏覽
相關問題
0 條評論
請先 登錄 后評論
admin
0 篇文章
作家榜 ?
-
 xiaonan123
189 文章
xiaonan123
189 文章
-
 湯依妹兒
97 文章
湯依妹兒
97 文章
-
 luogf229
46 文章
luogf229
46 文章
-
 jy02406749
45 文章
jy02406749
45 文章
-
 小凡
34 文章
小凡
34 文章
-
 Daisy萌
32 文章
Daisy萌
32 文章
-
 我的QQ3117863681
24 文章
我的QQ3117863681
24 文章
-
 華志健
23 文章
華志健
23 文章
推薦文章
- 為什么我晚上腿抽筋(do I get Leg Cramps at Night)?
- 什么是維生素D燈(Vitamin D Lamp)?
- 什么是病毒載量(Viral Load)?
- 胍法辛對兒童安全嗎(Safe Is Guanfacine for Children)?
- 什么是胚胎瘤(Blastoma)?
- 什么是戊酸倍他米松(Betamethasone Valerate)?
- 什么是低氧血癥(Hypoxemia)?
- 什么是木鎖油(Wood Lock&Reg; Oil)?
- 兒童腦癱有哪些特點(Characteristics of Cerebral Palsy in Children)?
- 賴氨酸和脫發之間有什么聯系(the Connection between Lysine and Hair Loss)?
- 什么是霉菌瘤(Mycetoma)?
- 什么是冷凍手術(Cryosurgery)?
- 什么是能量場(Energy Field)?
- 我怎么知道我是否有紅霉素過敏(Know If I an Erythromycin Allergy)?
- 手指麻木最常見的原因是什么(Most Common Causes of a Numb Finger)?
- 我怎樣治療皮膚干燥(Treat Dry Skin)?
- 什么是胃潰瘍出血(Bleeding Stomach Ulcer)?
- 什么是透析移植物(Dialysis Graft)?
- 什么是龜頭炎(Balanitis)?
- 什么是康復治療(Rehabilitation Therapy)?
- 嬰兒結膜炎有哪些癥狀(Symptoms of Conjunctivitis in Babies)?
- 什么是治療性危機干預(Therapeutic Crisis Intervention)?
- 最常見的腳部問題是什么(Most Common Types of Foot Problem)?
- 阿托伐他汀和辛伐他汀治療有什么區別(Differences between Atorvastatin and Simvastatin Treatments)?
- 什么是感覺異常的肌肉痛(Meralgia Paresthetica)?
- 什么是外部男性導管(External Male Catheter)?
- 什么是生殖健康(Reproductive Health)?
- 肝硬化的階段是什么(Stages of Cirrhosis)?
- 4D超聲波有多安全(Safe is 4D Ultrasound)?
- 什么是精神病控制(Psychiatric Hold)?